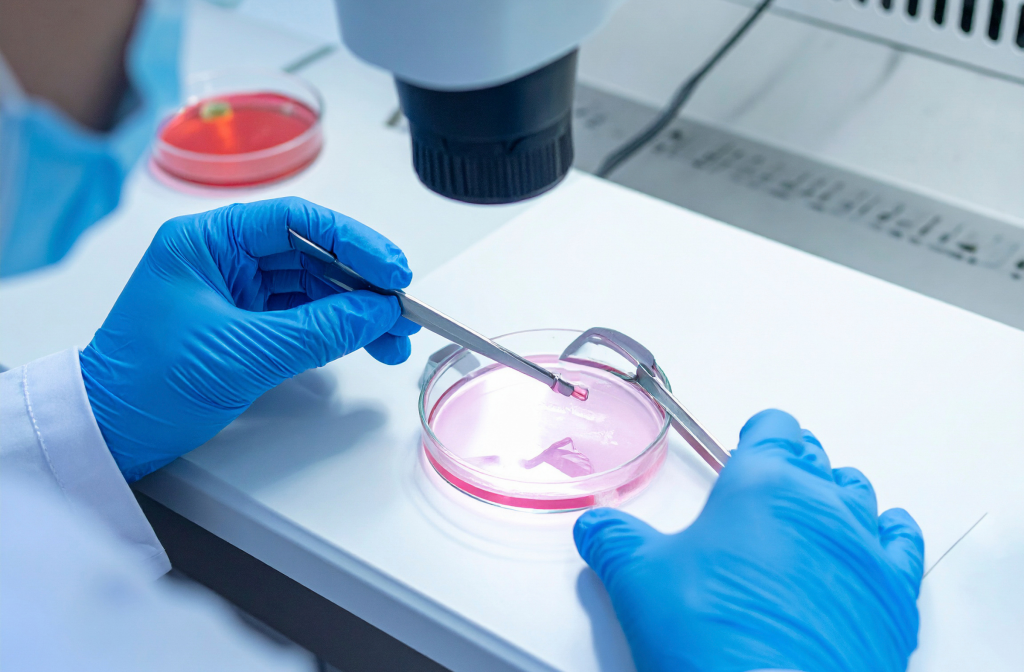
Close-up of IVF laboratory work showing an embryo being handled under a microscope

Planning and building a family as an LGBTQ+ individual or couple often presents particular challenges, not necessarily experienced by a heterosexual person or couple.
One of the major matters you will have to deal with is the financial implications.
It is vitally important that you engage the services of a financial advisor at the very start of your journey.
A financial advisor will be able to offer you advice tailored to your own circumstances and create an all important budget plan. They will take into account the parenting method you choose, as well as alerting you to the many unanticipated costs you may encounter along the way.
The costs for a same-sex couple looking to start a family will depend very much on the chosen route in building a family, with IUI, IVF, surrogacy and adoption or fostering all incurring different charges and considerations.
Costs will also depend heavily on the choice of clinic, location, the required number of cycles, and individual circumstances.

IUI (Intra-Uterine Insemination) which is often used by female same-sex couples can cost up to £1,600 per cycle. However, as many providers require multiple IUI cycles, you should bear in mind that costs can quickly add up. If donor sperm is required then that’s an additional expenditure (approximately £1,000 per sample).
Taking all this into account, a female couple going down the IUI route should be looking at spending upwards of £6,000, and depending on the number of cycles required this may be even higher
Alternatively, IVF (In Vitro Fertilisation) with donor sperm, donor eggs or donor embryos, or Reciprocal IVF (“Shared Motherhood”), can cost between £5,000 to £10,000.
However, IVF does not guarantee success and you should factor in multiple cycles, and budget accordingly. An outlay of £25,000+ is not uncommon.

The Surrogacy option for male same-sex couples is considerably higher and you will be looking to pay from £50,000 to £70,000 or more. This covers not just medical expenses, but legal and agency fees, surrogate expenses including compensation and insurance, counseling and other practical and medical support. Surrogacy is non-commercial in the UK, but if you choose international surrogacy then the costs incurred will be even higher.

Adoption can often be the cheapest option. Adoption agencies in the UK do not charge prospective parents for the adoption itself, but outgoings such as admin, legal and travel and home preparation costs should be taken into consideration. International adoption costs vary widely depending on the destination, agency fees, visa and naturalisation expenses.

Co-parenting agreements, where you plan to raise a child with a platonic partner, is another adoption, but that also involves budgeting for legal and associated expenses.
In addition to all the upfront costs, you must also budget for ongoing and future costs such as child-raising and childcare costs, parental leave expenses, tax and insurance matters, and housing.
Your financial advisor will also be able to make clear to you all the costs involved in planning and building a family, and also advise you on what financial help, if any, may be available to you.
However, it is important to realise that, whatever grants or assistance there may be available to same-sex couples, they very rarely cover all the costs.